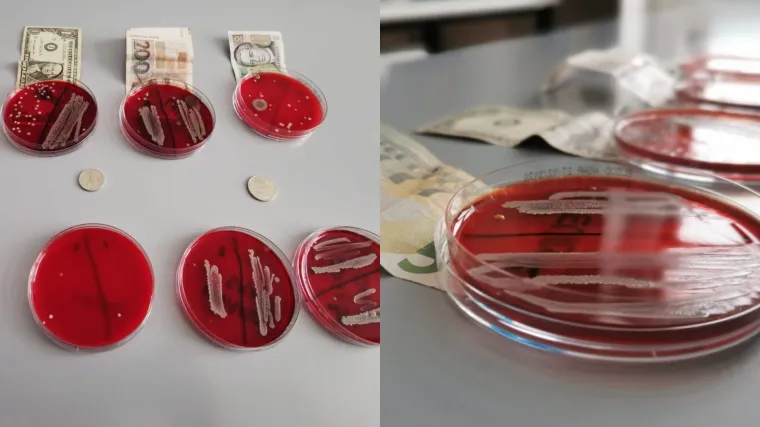
Vreba li koronavirus i s novčanica? Obavili smo laboratorijsku analizu, rezultati su &scaron;okantni!

Vreba li koronavirus i s novčanica? Obavili smo laboratorijsku analizu, rezultati su šokantni!
13. - nakon 24 sata zatišja potvrđen je još jedan slučaj koronavirusa u Hrvatskoj! Novi radni tjedan donio nam je i nove, strože mjere. Obaveznu karantenu za sve koji dolaze iz žarišta - a samo u zadnja 24 sata u Hrvatsku je ušlo 600 Talijana - te preporuku otkazivanja svih okupljanja s više od tisuću ljudi, bilo u zatvorenom, bilo na otvorenom.
Danas je tako odlučeno da se za jesen odgodi niz događaja, a večeras je službeno odgođen i festival Zagreb Dox.
I dalje nas uvjeravaju kako je u Hrvatskoj dobra epidemiološka situacija sa "samo" 13 oboljelih, ali i da je baš sada pravi trenutak da se uvedu mjere kako bi se spriječilo povećanje tog broja.
Markotić za RTL o 13. slučaju koronavirusa i strožim mjerama: 'Virus se ne ponaša po pravilima...'
Mi smo pak dobili rezultate naše prošlotjedne laboratorijske analize novčanica, i s njima potvrdu da bi one mogle biti utočište raznih bakterija i virusa.
Tisuće ljudi bile su na subotnjem koncertu Nine Badrić u zagrebačkoj Areni...
Samo dva dana kasnije:
"Na taj način se preporučuje odgoditi sve skupove i organizirana događanja na kojima sudjeluje više od tisuću ljudi", kazao je ministar unutarnjih poslova Davor Božinović.
A takvih događanja je hrpa od velikog koncerta Opće opasnosti u Spaladium Areni do gotovo svakodnevnih koncerata u Lisinskom.
Do kraja mjeseca zakazana su 34 događanja uključujući koncerte i predstave. U veliku dvoranu stane više od 1800 posjetitelja, a neki koncerti bili su rasprodani: dva novosadskog benda Frajle i Miroslava Škore.
Zbog panike oko koronavirusa neki posjetitelji odlučili su vratiti karte, a službenog očitovanja hoće li koncerti biti otkazani još nema. Svi organizatori morati će osigurati punktove s dezinfekcijskim sredstvima.
"Bit će što će biti. Ako treba zabraniti... ne zabraniti, odgoditi taj koncert mi ćemo ga odgoditi u interesu zdravlja, zdravlje je prije svega", poručuje Škoro.
Korona je otkazala Dane komunikacija u Rovinju, inovacijski summit Digital Takeover, Festival svjetla i Međunarodni sajam turizma.
Rezultati naše analize
Već sada je jasno da bi baš turizam mogao pretrpjeti najveću štetu. Talijani i ostali stranci koji dolaze u Hrvatsku, a bili su u žarišnim područjima odmah lete u karantenu, a Hrvati u dvotjednu izolaciju.
"Imamo situaciju da talijanski građani i dalje dolaze kod nas, mogu vam reći da je u zadnjih 24 sata 600 talijanskih državljana ušlo u Hrvatsku, do sada su se trebali javljati epidemiolozima, a sada idu u karantenu", ističe ravnatelj HZJZ-a Krunoslav Capak.
Korona je i dalje nepoznanica koja bi mogla vrebati čak i iz novčanica pa smo prošli tjedan na analizu odnijeli kune, eure i dolare da vidimo koliko bakterija i virusa nosimo u svojim novčanicama.
Leglo bakterija... Najviše ih je na novčanici od 5 eura, a najmanje na 10 kuna.
"Na novčanici od 200 kuna imamo jako, jako puno bakterija. Na novčanici od dolara s jedne strane imamo više s druge strane manje, ali jednako tako puno. Euro od papirnatih novčanica je prepun bakterija, to nisam tako očekivala, zaista puno. Na novčanici od jedne kune jako malo bakterija, međutim novčanice od 5 kuna su najgore od kovanica", govori Jasna Hrenović sa Zavoda za mikrobiologiju PMF-a.
Na papirnatima novčanicama ova odvratna stvorenja mogu preživjeti mjesec dana, a na kovanicama tjedan.
Perite ruke i dezinficirajte stvari
"Možda će kolege razumjeti ako pokažem na ovu bakteriju.
Naravno da ćemo tu bakteriju prenijeti zajedno s tom
novčanicom. I diranje te novčanice može rezultirati time da
dobijemo jednu bakteriju.
Potvrđen i 13. oboljeli od koronavirusa u Hrvatskoj: U bolnici je u Puli, radio je u Italiji...
Jednako koliko ih ima na novčanicama, ima ih na ključevima i mobitelima.
"Zato jer po istom principu kao što mikroorganizme prenosimo s ruku na novčanice tako ćemo ih prenijeti i na mobiteli i ključeve. Možemo ih naći tisuću na jedan cm. Prema zadnjim istraživanjima pokazano je da korona virus na ovakvim površinama može preživjeti 9 pa čak do 28 dana", jasno će Hrenović.
Bakterija i virusa na novčanicama, ključevima i mobitelima možemo se koliko toliko riješiti.
"Pa ja kao biolog bi rekla da dezinficiramo sa 70 postotnim alkoholom možda etanolom, a novčanice stavimo u sušilicu i ona će ih ubiti sve", govori Hrenović.
Perite ruke i dezinficirajte stvari koje koristite svakodnevno, a poznata su legla bakterija.





403 Forbidden





 EP RUKOMET
EP RUKOMET




